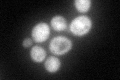
YOR323C
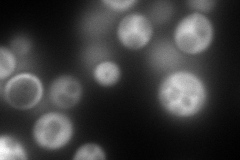
YOR323C
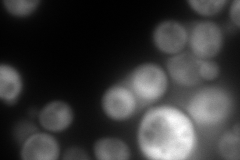
YOR323C
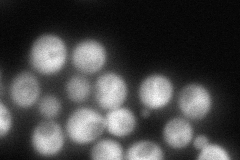
YOR323C
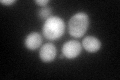
YOR323C
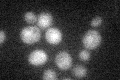
YOR323C

View description
Gamma-glutamyl phosphate reductase, catalyzes the second step in proline biosynthesis
Localization:
Intensity:
Fold change:
Significance:
-
C’ GFP library in SD
cytosol67.68 -
N' NOP1pr-GFP in SD
cytosol360.632 -
N' TEF2pr-mCherry in SD
cytosol333.906 -
N' NATIVEpr-GFP in SD
cytosol110.649 -
N' TEF2pr-VC and Cyto-VN in SD

ambigous78.0368 -
C’ GFP library in SD+DTT
cytosol46.790.69No -
C’ GFP library in SD+H2O2

cytosol76.221.12No -
C’ GFP library in Starvation Media
cytosol30.370.44No -
C’ GFP library on the background of Pup2-DaMP

cytosol -
C’ GFP library on the background of CCT mutant

cytosol60.12870.888332No
